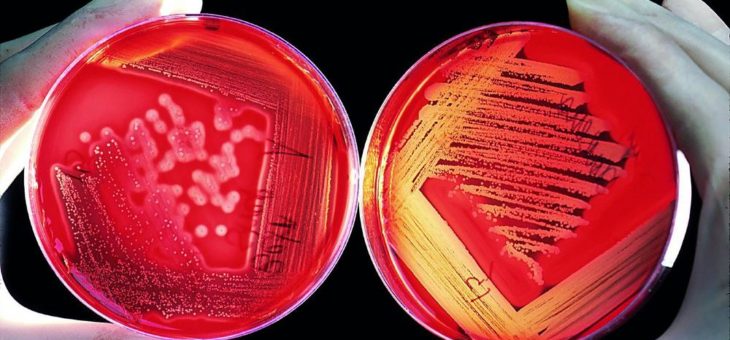

HOTLINE der Kinder- und Jugendpsychiatrie zur Unterstützung bei Familienkrisen in der Vorweihnachtszeit
Stress und hohe Erwartungen in der Vorweihnachtszeit können in Familien zu außergewöhnlichen Belastungen und zu psychischen Krisen führen. Die Kinder- und Jugendpsychiatrie (KJPP) im Klinikum Christophsbad möchte einen Beitrag dazu leisten, dass die Adventszeit, die Weihnachtsfeiertage und der Jahreswechsel für Familien eine Zeit der Erholung, des Ausruhens, auch des Innehaltens und des Besinnens werden kann.Read more about HOTLINE der Kinder- und Jugendpsychiatrie zur Unterstützung bei Familienkrisen in der Vorweihnachtszeit[…]